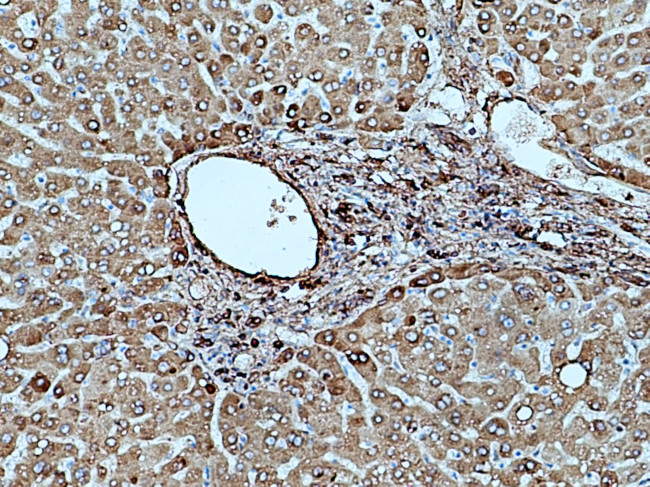
Fibrinogen gamma chain Antibody in Immunohistochemistry (Paraffin) (IHC (P))

Search
Proteintech
Fibrinogen gamma chain Polyclonal Antibody
{{$productOrderCtrl.translations['antibody.pdp.commerceCard.promotion.promotions']}}
{{$productOrderCtrl.translations['antibody.pdp.commerceCard.promotion.viewpromo']}}
{{$productOrderCtrl.translations['antibody.pdp.commerceCard.promotion.promocode']}}: {{promo.promoCode}} {{promo.promoTitle}} {{promo.promoDescription}}. {{$productOrderCtrl.translations['antibody.pdp.commerceCard.promotion.learnmore']}}
图: 1 / 6
Fibrinogen gamma chain Antibody (15841-1-AP) in IHC (P)






产品信息
15841-1-AP
种属反应
已发表种属
宿主/亚型
分类
类型
抗原
偶联物
形式
浓度
规格
纯化类型
保存液
内含物
保存条件
运输条件
产品详细信息
Immunogen sequence: IQLTYNPDE SSKPNMIDAA TLKSRKMLEE IMKYEASILT HDSSIRYLQE IYNSNNQKIV NLKEKVAQLE AQCQEPCKDT VQIHDITGKD CQDIANKGAK QSGLYFIKPL KANQQFLVYC EIDGSGNGWT VFQKRLDGSV DFKKNWIQYK EGFGHLSPTG TTEFWLGNEK IHLISTQSAI PYALRVELED WNGRTSTADY AMFKVGPEAD KYRLTYAYFA GGDAGDAFDG FDFGDDPSDK FFTSHNGMQF STWDNDNDKF EGNCAEQDGS GWWMNKCHAG HLNGVYYQGG TYSKASTPNG YDNGIIWATW KTRWYSMKKT TMKIIPFNRL TIGEGQQHHL GGAKQAGDV (90-437 aa encoded by BC007044)
靶标信息
The protein encoded by this gene is the gamma component of fibrinogen, a blood-borne glycoprotein comprised of three pairs of nonidentical polypeptide chains. Following vascular injury, fibrinogen is cleaved by thrombin to form fibrin which is the most abundant component of blood clots. In addition, various cleavage products of fibrinogen and fibrin regulate cell adhesion and spreading, display vasoconstrictor and chemotactic activities, and are mitogens for several cell types. Mutations in this gene lead to several disorders, including dysfibrinogenemia, hypofibrinogenemia and thrombophilia. Alternative splicing results in two transcript variants encoding different isoforms.
仅用于科研。不用于诊断过程。未经明确授权不得转售。
生物信息学
蛋白别名: fibg; Fibrinogen gamma chain; fibrinogen gamma-chain; fibrinogen, gamma polypeptide; gamma-fibrinogen; testicular tissue protein Li 70; unnamed protein product
基因别名: 3010002H13Rik; AI256424; FGG; PRO2061
UniProt ID: (Human) P02679, (Mouse) Q8VCM7, (Rat) P02680
Entrez Gene ID: (Human) 2266, (Mouse) 99571, (Rat) 24367